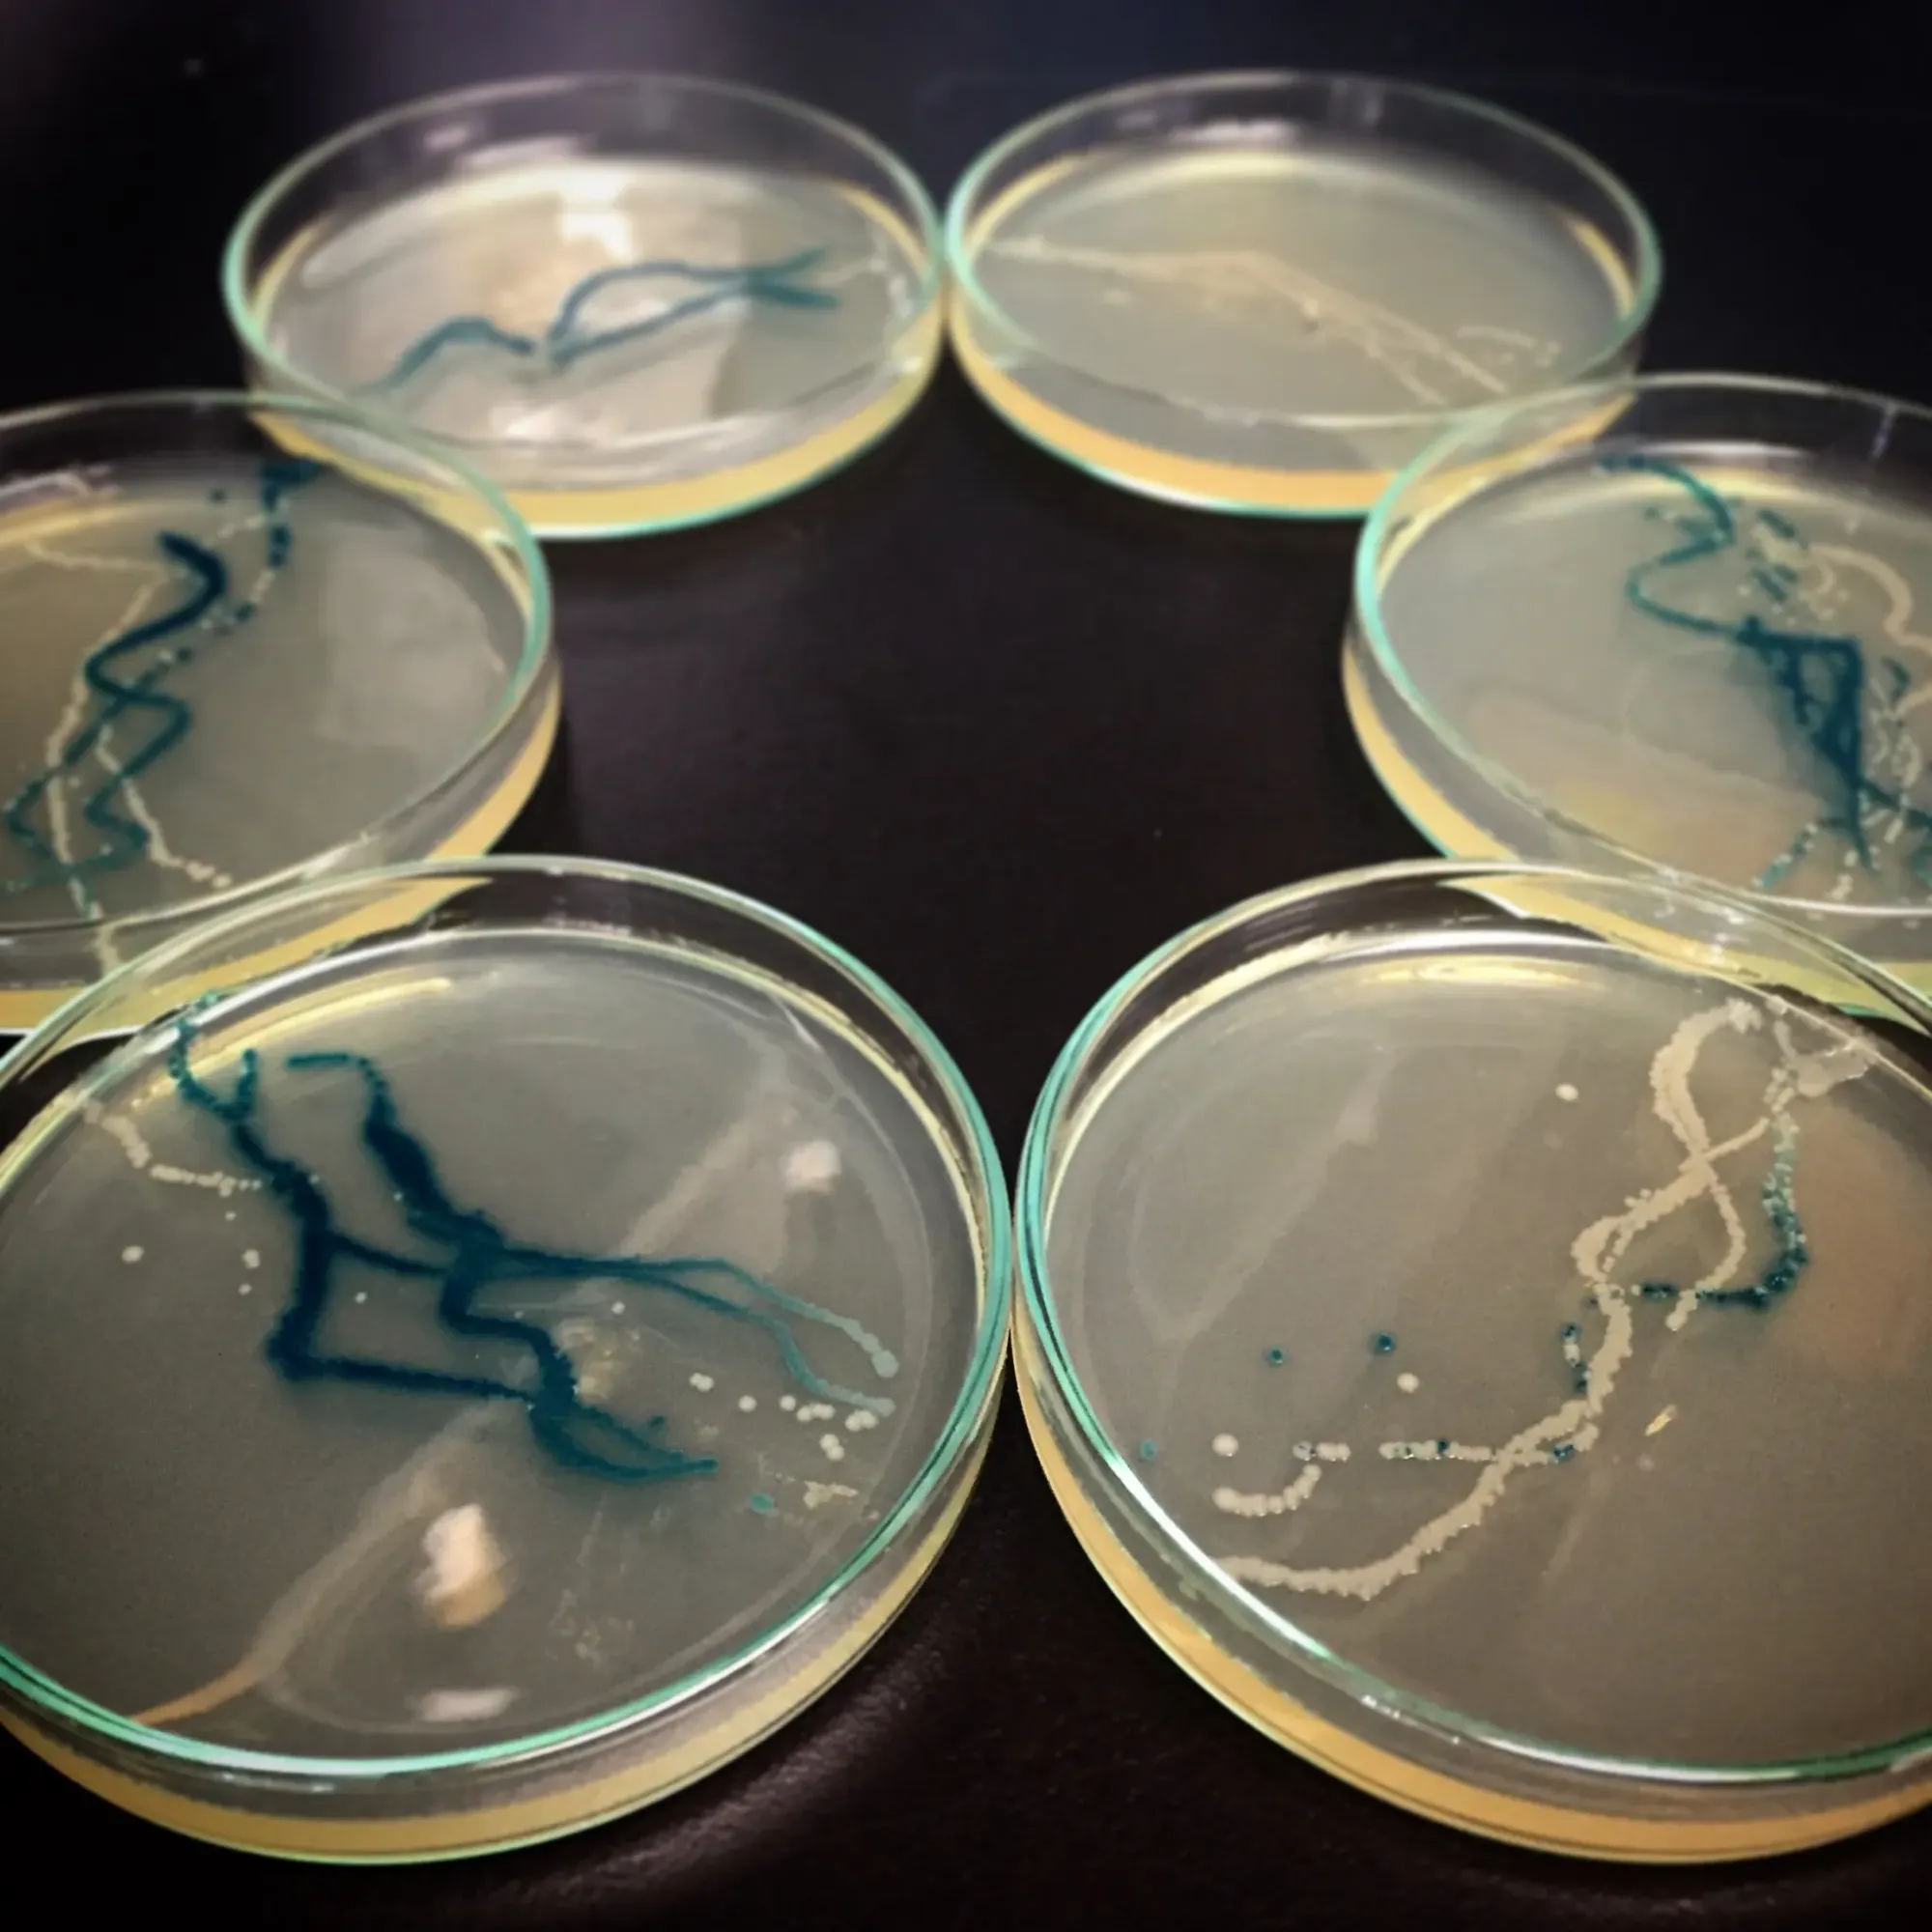

Design is often thought of as an act of mastery—of shaping materials, directing systems, and orchestrating outcomes. But as designers increasingly turn toward biology, ecology, and decentralized computation, a different paradigm is gaining traction: emergence. Rather than tightly managing systems, designers are learning to co-author with them, embedding agency into matter and letting intelligence unfold from the bottom up.
This isn’t just about biomimicry or aesthetics inspired by nature. It's about working with living and life-like systems—mosses, bacteria, synthetic cells, and machine-learning agents—on their own terms. The resulting design processes challenge conventional notions of authorship and control, privileging interaction, feedback, and unpredictability. This shift has profound implications for how we build, program, and imagine futures.
Slime Mold as a Design Collaborator
Few organisms embody emergence more clearly than Physarum polycephalum, a brainless slime mold capable of solving mazes and optimizing networks. In 2017, at the Institute for Advanced Architecture of Catalonia (IAAC), students explore bio-inspired systems in architecture through the project “Living Screens”—an experiment using Physarum to generate adaptive design strategies.

In Living Screens, slime mold is cultivated across nutrient grids, and its self-organizing growth patterns are translated into facade and structural design logic. Rather than imposing form, the designers curate conditions that allow biological intelligence to emerge. This process reflects a growing interest in responsive, decentralized systems—where control shifts from top-down directives to environmental feedback, and design becomes a negotiation between organic and computational processes.

Bacterial Intelligence in Art and Infrastructure
Artist and researcher Anna Dumitriu has long worked with microbiology to explore ethics, agency, and the porous boundary between human and microbial systems. Her installation “Engineered Antibody” (2020), created in collaboration with Dr. Jane Freeman and Dr. James Price, used CRISPR-edited E. coli bacteria to encode an artificial antibody sequence—making visible the interplay between synthetic biology and human disease response.

Rather than creating a static object, Dumitriu treats bacterial life as both medium and co-creator. Her work poses an open question: what does it mean to design when your materials evolve, mutate, and replicate autonomously?

This kind of practice demands both scientific literacy and ethical caution. But it also gestures toward design futures where control gives way to cultivation—shaping not specific forms, but ecosystems of possibility.
Growing Computation
At the Massachusetts Institute of Technology’s Mediated Matter Group, the now-retired Aguahoja project exemplified this approach through the use of biologically derived materials like chitosan, cellulose, and pectin. Led by Neri Oxman, the team produced architectural structures that could biodegrade, regenerate, or transform based on environmental triggers.

Aguahoja was not simply sustainable by design. It was emergent in structure and behavior—shaped by material properties, moisture levels, and growth patterns more than human precision. The printed components curled, shrank, or flexed in response to humidity. Control was shared between digital fabrication and the material intelligence of biopolymers. In such cases, computation isn’t just an algorithm—it’s embedded in how living systems process energy, respond to stimuli, or reorganize themselves over time. The designer becomes more gardener than engineer, guiding but not commanding.
Swarms, Signals, and Soft Robotics
Emergence isn't confined to the microbial or molecular. The XenoBot project, created by researchers at Tufts University and the University of Vermont, designed programmable living machines using frog stem cells. These soft-bodied organisms could move, carry payloads, and even self-replicate under certain conditions—without a central nervous system or pre-defined programming.

XenoBots operate based on emergent behavior: local rules guiding cells lead to collective, adaptive action. While the ethics of such systems remain contested, their design demonstrates the power of biological computation and decentralized control. They’re not engineered to follow orders—they're cultured to respond. Similar principles are being explored in synthetic swarms and decentralized robotic systems, including in work by roboticist Radhika Nagpal at Princeton (formerly Harvard). Her Kilobot swarm project used hundreds of simple robots to explore how local interaction rules could produce global behaviors, offering insights for everything from search-and-rescue robots to distributed sensing systems.

Designing Conditions, Not Commands
What binds these projects is not a shared technology, but a shared philosophy: the relinquishing of centralized control in favor of systemic responsiveness. Instead of predefined paths and outcomes, these designs set up interactions—among cells, materials, or agents—and let patterns emerge. This doesn’t mean giving up on intention or precision. It means designing with a different understanding of what those things look like. Rather than locking down outcomes, designers craft affordances, constraints, and parameters within which life—or something like it—can thrive. It also introduces a new model of authorship. When intelligence is distributed—across cells, sensors, or code—no single hand is in charge. Instead, design becomes a negotiation with material systems and the rules they already follow.
Implications for the Future of Design
As interest in regenerative systems, environmental computation, and post-anthropocentric design grows, these approaches will only become more relevant. They offer models not just for sustainability, but for adaptability and resilience—qualities increasingly urgent in the face of global instability. They also force a reevaluation of power in design. Who—or what—is in control? And what might it mean to surrender control in pursuit of more generative, entangled futures?
The lesson from emergence is clear: intelligence doesn’t need to be imposed from above. Sometimes, it’s already in the system—waiting for the right conditions to unfold.